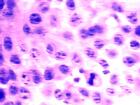
組織器官

重要意義
在國與國之間的競爭越來越體現在科技實力的今天,對應組織器官工程這一具有巨大市場潛力的領域,我們如果全方位
 組織器官
組織器官遵循原則
 組織器官
組織器官組織分類
 組織器官
組織器官
組織器官,是動物生物學中的專業術語,是一種比組織的等級高,當時沒有具體形態和功能的器官。
在國與國之間的競爭越來越體現在科技實力的今天,對應組織器官工程這一具有巨大市場潛力的領域,我們如果全方位
組織器官
組織器官 組織器官
組織器官 組織器官
組織器官聽覺器官是感受聲波的裝置,藉助聽覺器官,動物能夠獲得遠距離的信息,藉以交往、尋偶、躲避敵害、捕捉獵物,因而對生命活動具有重要意義。
器官組成 人耳聽閾 傳音作用 感音換能 動作電位病理聲像圖 病理聲像圖 病理聲像圖
由於醫療技術的不斷進步,器官移植的種類越來越多,成功率越來越高,許多患者都可以通過器官移植來延續生命。然而在現實中,由於器官短缺,遠遠不能滿足移植的需求...
介紹 捐贈範圍 種類 腦死亡與器官捐贈 器官移植第十章 第十三章 超聲造影在淺表器官中的套用
圖書信息 內容簡介 目錄器官發生,亦稱器官形成,一般指脊椎動物個體發育中,由器官原基進而演變為器官的過程。各種器官形成的時間有早有晚,通過器官發生階段,各種器官經過形態發生和組...
簡介 過程 因素老年人多器官功能不全綜合徵是導致老年危重病患者死亡的重要原因。由於老年多器官功能不全的發生是兩個或兩個以上器官同時或序貫式的發病,過程類似於多米諾骨牌現...
疾病概述 症狀體徵 發病機制 發病環節 診斷檢查肝是脊椎動物身體內以代謝功能為主的一個器官,並在身體裡面扮演著去氧化,儲存肝糖,分泌性蛋白質的合成等,也製造消化系統中的膽汁。肝位於人體腹部位置,在右側...
科技名詞定義 位置 再生 功能 解剖學4、 4、 4、
離體組織器官恆溫灌流系統簡介 SV-4型系統介紹 HV-4型系統介紹 儀器保養與維護